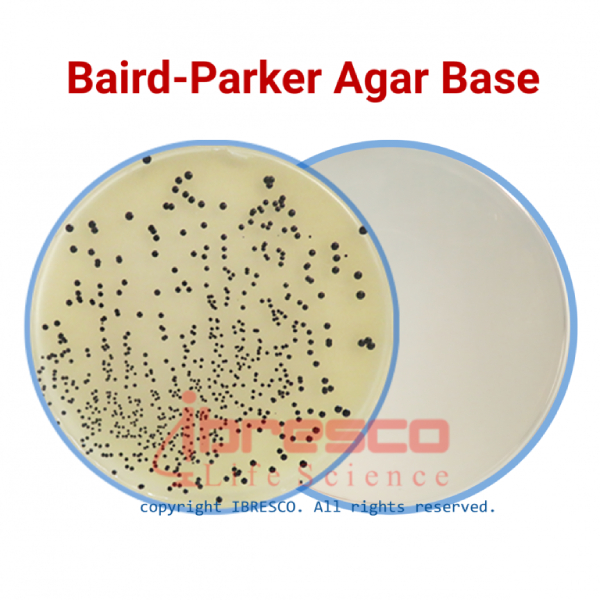

فروش محیط کشت برد-پارکر آگار بیس ایبرسکو
تمادکالا فروشگاه اینترنتی فعال در حوزه فروش محیط کشت است که در زمینه فروش محیط کشت برد-پارکر آگار بیس با برند ایبرسکو فعالیت میکند. ایبرسکو از شرکتهای فعال در زمینه محیط های کشت و محصولات میکروبی در کشور است. جهت کسب اطلاعات بیشتر از این محیط کشت به ادامه مطلب مراجعه نمایید.
محیط کشت میکروبی Baird Parker Agar Base یا برد پارکر آگار بیس مناسب برای کشت Staphylococcus aureus و برای جداسازی و تمایز استافیلوکوکهای کواگولاز مثبت در آزمایشهای غذایی و دارویی کاربرد دارد. این محیط برای تشخیص بیماریها و سایر وضعیتهای مربوط به انسان استفاده نمیشود.
این محیط کشت حاوی پپتون کازئین و عصاره گوشت به عنوان تامین کننده نیتروژن برای رشد باکتری است. برای کمک به نیتروژن و مواد مغذی ضروری از جمله ویتامین B12 عصاره مخمر در این محیط اضافه شده است. لیتیم کلرید و تلوریت (در زرده تخم مرغ با امولسیون تلوریت) آلایندهها را مهار کرده و از رشد گونه های coliform جلوگیری میکند و تلورید ایجاد شده توسط Staphylococcus aureus کاهش مییابد که به طور معمول کلونی های سیاه رنگ ایجاد میکند. گلیسین و سدیم پیروات رشد استافیلوکوک را افزایش میدهند. پیروات پروکسیدهای سمی ایجاد شده در محیط کشت را خنثی میکند.
زرده تخم مرغ با افزودن امولسیون تلوریت باعث ایجاد یک محیط زرد و کمی مات میشود. ظاهر یک هاله شفاف و کلنیهای خاکستری سیاه نشان دهنده استافیلوکوکهای احتمالی کواگولاز مثبت است، زیرا ارتباط قوی بین تست کواگولاز و فعالیت لیپولیتیک وجود دارد.
برد پارکر آگار، وقتی با فیبرینوژن پلاسمای خرگوش ترکیب میشود، امکان تشخیص فعالیت کواگولاز را فراهم میکند، با ارگانیسمهای مثبت که کلنیهای خاکستری تا سیاه احاطه شده توسط هالهای مات را نشان میدهند. این آگار این مزیت را دارد که نیاز به آزمایش کواگولاز اضافی را کاهش می دهد. همچنین این محیط می تواند رشد گونههای پروتئوس را در صورت مصرف مکمل سولفامتازین کاهش دهد.
ویژگیها
- محیط کشتی بسیار انتخابی به علت وجود پتاسیم تلوریت و لیتیوم کلراید و سدیم پیروات
- طبق استانداردهای: ISO, USP, EP, DIN
- سایر ویژگیها به همراه مواد موجود در محیط در کاتالوگ محصول قابل مشاهده است.
کاربرد
- برای جداسازی و شمارش استافیلوکوکوس اورئوس در مواد غذایی، دارویی، آرایشی و بهداشتی و نمونههای بالینی
آماده سازی محیط برد – پارکر آگار بیس
- 58 گرم از محیط را در 950 میلی لیتر آب مقطر حل نمایید. قبل از آن قوطی حاوی محیط را به خوبی تکان دهید.
- حرارت داده تا پودر محیط در آب به طور کامل حل شود.
- در دمای 121 درجه سلسیوس به مدت 15 دقیقه اتوکلاو کنید.
- پس از اتوکلاو، محیط را تا دمای 45-50 درجه سلسیوس سرد کنید و مقدار 50 میلی لیتر از امولسیون زرده تخم مرغ-داری تلوریت به آن اضافه کنید.
- محلول محیط کشت را به آرامی تکان دهید تا کاملا مخلوط شود. سپس در پلیت پخش کنید.
نحوه آزمایش برد – پارکر آگار بیس
- سطح پلیت محیط کشت را قبل از تلقیح، در زمان کوتاه و به سرعت، خشک کنید.
- نمونه غذایی مورد نظر را در آب یا محیط کشت Buffered Peptone Water بخیسانید و مطابق پروتکل مربوطه، از آن رقت تهیه کنید.
- مقدار 0.1 تا 0.5 میلی لیتر از نمونه را بر روی پلیت تلقیح کرده و کاملا در سطح آن پخش کنید.
- پلیت های تلقیح شده را به مدت 24-48 ساعت در دمای 35 درجه سلسیوس گرما دهید.
نتیجه آزمایش
- کلنیهای تیپیکال باکتری استافیلوکوک اورئوس (کوآگولاز مثبت) در محیط کشت به رنگ سیاه، محدب و دارای هاله شفاف در اطراف هستند. استافیلوکوکهای کوآگولاز منفی معمولا در این محیط رشد نمیکنند و در صورت رشد هاله شفاف ندارند.
- سایر باکتریها نیز معمولا در این محیط رشد نکرده و در صورت رشد کلنیهایی به رنگ سفید یا قهوه ای تشکیل می دهند که فاقد هاله شفاف هستند.
کنترل کیفی برد – پارکر آگار بیس
- ظاهر محیط دهیدراته: کرم رنگ، پودری و یکنواخت
- ظاهر محیط آماده: زرد رنگ و مات
نکات مهم
- تمام کلنی های مشکوک به استافیلوکوک اورئوس را، با وجود واکنش های منفی، از محیط جدا کرده و با تست های تاییدی بعدی مورد بررسی قرار دهید.
- کلنی های برخی باکتری های غیرهدف که در نمونه وجود دارند و در نزدیکی کلنی های کوآگولاز مثبت رشد می کنند، ممکن است کمی تا قسمتی از واکنش هالو کوآگولاز را هضم کنند.
- به دلیل وجود لیتیوم کلراید در ترکیب، این محیط بسیار سمی است و از تماس محیط با پوست، چشم و از تنفس پودر محیط خودداری نمایید.
شرایط نگهداری
- پودر محیط داخل قوطی کاملا در بسته و در دمای زیر 30 درجه سلسیوس نگهداری شود.
- محیط آماده در دمای 2-8 درجه سلسیوس نگهداری شود.
- بهترین زمان استفاده تا قبل از تاریخ انقضای درج شده بر روی برچسب محصول است.
خرید محیط کشت برد-پارکر آگار بیس ایبرسکو
کلیه محصولات تمادکالا به صورت تضمین شده با کیفیت و قیمت مناسب به صورت اینترنتی به فروش رسیده و ارسال کلیه محصولات تمادکالا از طریق پست صورت می گیرد. شما می توانید با ثبت سفارش محصول محیط کشت برد – پارکر آگار بیس ایبرسکو را در کوتاه ترین زمان ممکن دریافت نمایید.